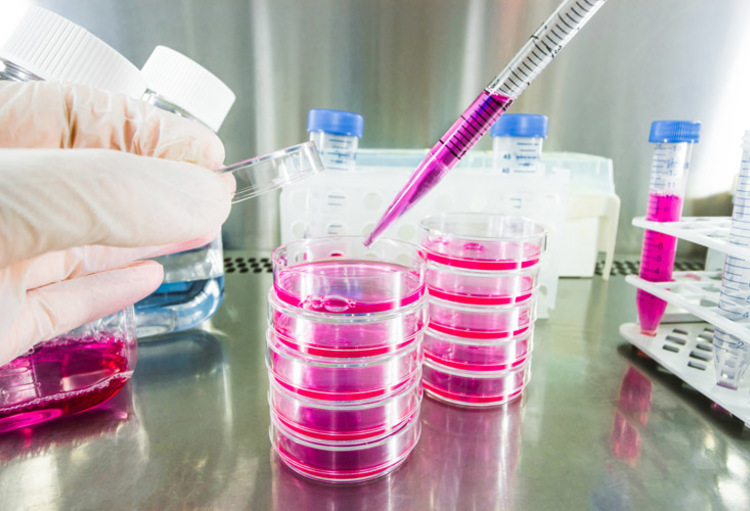

Lancée en 2014, l’entreprise limbourgeoise UgenTec planche sur des logiciels capables d’apporter un soutien aux laborantins, afin de leur permettre de se concentrer davantage sur leurs tâches fondamentales. Grâce à ces outils numériques et d’intelligence artificielle, non seulement le temps d’analyse des tableaux cliniques se trouve sensiblement réduit (parfois de 90 %), mais les résultats sont aussi plus précis.
La jeune firme a le vent en poupe et tente aujourd’hui de se positionner également sur le marché américain. Plus d’une centaine de laboratoires de tests moléculaires de par le monde utilisent déjà le système d’analyse automatisé d’UgenTec, en première instance pour l’analyse génétique dans un cadre diagnostique clinique, mais aussi de plus en plus dans d’autres domaines tels que la sécurité alimentaire ou l’agriculture.
Les laborantins s’attachent à amplifier et identifier des séquences d’ADN à l’aide de la technique de la PCR (polymerase chain reaction) – une analyse dont les résultats permettront ensuite de décider d’un éventuel traitement. UgenTech entend aujourd’hui optimiser les procédés classiques extrêmement chronophages utilisés dans ce contexte.
La firme a notamment fait savoir il y a peu que son logiciel FastTyper, reposant sur l’IA, était en mesure d’accélérer le génotypage de façon significative (jusqu’à 30x). L’interprétation des résultats aussi serait sensiblement améliorée. Cela ne signifie évidemment pas que le laborantin est mis “hors-jeu” par la technologie : le logiciel effectue simplement une sorte de tri, indiquant quels sont les échantillons qui nécessitent ou non un suivi humain. «Nous évacuons l’interprétation subjective», avait déjà souligné dans le passé le directeur d’exploitation Wouter Uten. Le logiciel décharge le laborantin ou biologiste clinique des tâches répétitives et abrutissantes, mais améliore aussi le flux de travail afin que les résultats aboutissent plus rapidement chez l’intervenant voulu… et pour le patient, bénéficier d’un diagnostic et donc d’un traitement plus précoce n’a évidemment pas de prix.
Lorsque l’on sait que ce sont des milliards de tests PCR en point final qui sont réalisés chaque année (et pas uniquement en médecine humaine), on comprend facilement qu’il s’agit là d’un marché énorme.
«Le FastTyper traduit parfaitement l’objectif de notre entreprise: apporter aux laboratoires partout dans le monde les technologies logicielles et d’intelligence artificielle les plus récentes, avec des applications allant des maladies infectieuses à la sécurité et à la qualité des aliments en passant par l’oncologie», a résumé Steven Verhoeven, le CEO d’UgenTec.
Steven Verhoeven a été recruté l’an dernier par Agilent Technologies à Boston.